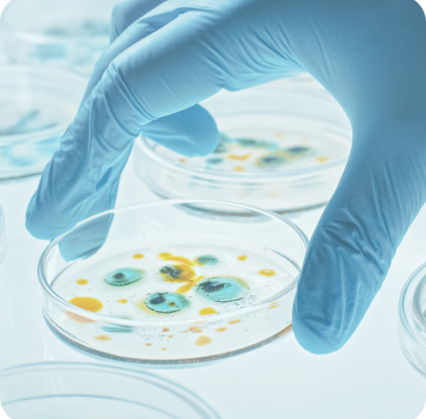
Efficacité

Chez Scineo, nous sommes convaincus qu'une science rigoureuse est un levier essentiel de création de valeur. Nous sommes également conscients des investissements importants et des risques d'échec associés. Forts de notre expertise, de notre réseau de partenaires, et de notre connaissance approfondie du secteur, nous vous proposons des solutions sur mesure et clé en main pour tester l'efficacité de vos produits. Nous adoptons une approche robuste mais pragmatique pour allier rigueur scientifique, maîtrise des budgets, respect des délais, et gestion des risques.
Démonstration de l'efficacité
Nous concevons les études scientifiques (non cliniques et cliniques), identifions les meilleurs partenaires et supervisons les études pour démontrer l'efficacité et la sécurité de vos produits.
Efficacité
Participer à la mise sur le marché de produits de santé sûrs et efficaces est au cœur de la raison d’être de Scineo. Dans un secteur de l'OTC et du Health Care en pleine mutation, la démonstration de l'efficacité des produits, qu'ils soient avec ou sans prescription, est devenue un élément de différenciation crucial pour leur succès commercial.
Autrefois dominé par l'empirisme, le marché des produits de santé familiale se structure désormais autour de preuves scientifiques solides. Cette évolution renforce la crédibilité du secteur, mais comporte aussi des risques : les échecs sont fréquents, et les investissements en R&D peuvent lourdement impacter le retour sur investissement (ROI). Pourtant, développer des produits efficaces et innovants, répondant aux besoins des patients-consommateurs et aux exigences réglementaires, représente une véritable opportunité de croissance.
Nos services pour évaluer l'efficacité:
Chez Scineo, nous vous proposons une approche globale pour valoriser vos produits au travers d’une science juste.
Contactez-nous dès aujourd'hui pour tester l’efficacité de vos produits.
Notre réseau
Leader d’opinions
Scineo s’entoure de KOL internationaux composés de médecins, cliniciens et chercheurs siégeant dans les plus grandes sociétés savantes internationales d’urologie, cardiologie, articulation, phytothérapie et nutrition.
Prestataires
Scineo collabore avec un réseau de prestataires qualifiés afin de conduire efficacement vos études cliniques et non cliniques et optimiser vos ressources.
Partenaires académiques
Scineo a des liens privilégiés avec des structures de recherche publique (INSERM, CNRS et INRAE) ainsi qu’avec des hôpitaux et universités de renom pour garantir la crédibilité de vos communications scientifiques.
Clients
Le portefeuille client de Scineo, composé à la fois de producteurs d’ingrédients, de développeurs, de structures Consumer Health Care et de grands groupes pharmaceutiques permet une mise en relation rapide et efficace des acteurs clés pour le développement de produits et concepts innovants.
Prêts à faire avancer vos projets ?
Contactez nous dès aujourd'hui pour découvrir comment Scineo peut vous accompagner dans votre réussite

Réinventons l'accompagnement scientifique pour les entreprises du secteur de la santé.

















